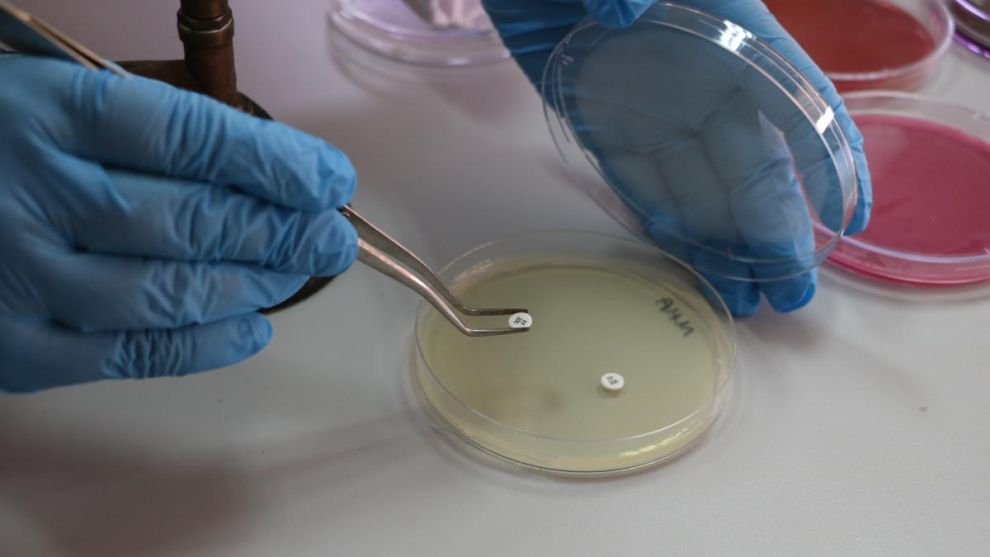

Çiğ Sütte Antibiyotik Dirençli Üropatojenik E. coli Tespit Edildiİnönü Üniversitesinde yürütülen araştırmada, Malatya genelinden toplanan çiğ süt örneklerinin üçte birinde çoklu antibiyotik direncine sahip üropatojenik E. coli (UPEC) bakterileri belirlendi. Araştırma, çiğ sütün hem gıda güvenliği hem de halk sağlığı açısından ciddi risk taşıyabileceğini ortaya koydu.Çiğ Sütte Antibiyotik Direnci ve UPEC Varlığı Ortaya Kondu
İnönü Üniversitesi Fen-Edebiyat Fakültesi Biyoteknoloji Anabilim Dalı Öğretim Üyesi Doç. Dr. Seval Cing Yıldırım yürütücülüğünde gerçekleştirilen ve BAP Birimi tarafından desteklenen çalışma kapsamında, Malatya’nın farklı noktalarından toplanan çiğ süt örnekleri üzerinde mikrobiyolojik analizler yapıldı. Araştırma sonucunda çiğ sütlerin kayda değer bir bölümünde antibiyotik dirençli ve virülans genleri taşıyan Üropatojenik Escherichia coli (UPEC) tespit edildi.
Doç. Dr. Yıldırım, elde edilen verilerin çiğ sütün yalnızca gıda güvenliği açısından değil, halk sağlığı yönünden de risk oluşturabileceğini ileterek çiğ süt tüketiminde dikkatli olunması gerektiğini aktardı.
“Çiğ süt hastalık yapıcı bakteriler için uygun bir taşıyıcı olabilir”
Çiğ sütün neden risk taşıdığına ilişkin değerlendirmelerde bulunan Doç. Dr. Yıldırım, kontrolsüz antibiyotik kullanımı, farklı çiftliklerden gelen sütlerin aynı tanklarda toplanması, çevresel etkenler ve modern üretim zincirinin oluşturduğu karma yapının bakteri çeşitliliğini artırdığını belirterek şunları söyledi:
“Bu risklerin arkasında, hayvancılıkta uzun süreli ve kontrolsüz antibiyotik kullanımı, farklı çiftliklerden gelen sütlerin aynı tanklarda toplanarak mikrobiyal çeşitliliğin artması, çevresel etmenlerle bakterilerin genetik yapılarında meydana gelen adaptasyonlar ve modern üretim zincirinin bu mikroorganizmaların yayılımını kolaylaştırması gibi unsurlar yer alıyor. Tüm bu faktörler çiğ sütü görünürde doğal bir ürün olmasına rağmen hastalık yapıcı genetik özellikleri taşıyabilen mikroorganizmalar için elverişli bir ortam haline getiriyor.”
122 Çiğ Süt Örneğinin Üçte Birinde UPEC Tespit Edildi
Araştırma kapsamında Malatya genelinden 122 çiğ süt örneği toplandı. Moleküler incelemeler sonucunda, her üç örnekten birinde çoklu antibiyotik direnci gösteren ve virülans genleri ile zenginleşmiş UPEC suşlarına rastlandı.
Üropatojenik E. coli’nin çiğ süt yoluyla sindirim sistemine girip belirti vermeden üriner sisteme ulaşabileceğini dikkat çekerek açıklayan Yıldırım, çalışmanın gıdayla ilişkili yeni bir enfeksiyon modelini ortaya koyduğunu aktardı.
“Virülans genleri yüksek, antibiyotik direnci yaygın”
Elde edilen laboratuvar sonuçlarının UPEC riskini net şekilde gösterdiğini ifade eden Doç. Dr. Yıldırım, çiğ sütteki E. coli suşlarının büyük bölümünün virülans genetik belirteçlerine sahip olduğunu vurgulayarak şöyle konuştu:
“Çalışmada izole edilen E. coli suşlarının önemli bir kısmı, idrar yolu enfeksiyonlarına neden olabilen üropatojenik E. coli (UPEC) grubuna ait genetik belirteçleri taşımaktadır. Moleküler analizlerde 10 farklı virülans geni tarandı. Özellikle fimA (yüzde 98.5) ve agn43 (yüzde 95.6) gibi virülans genlerinin yüksek oranda bulunması, bu bakterilerin idrar yollarına tutunma, biyofilm oluşturma ve bağışıklık sisteminden kaçma yeteneklerine sahip olduğunu göstermektedir. Antibiyotik duyarlılık testlerinde tüm izolatların sefalotine karşı yüzde 100 dirençli olduğu; ayrıca yüzde 65,2’sinin çoklu antibiyotik direnci sergilediği belirlendi.”
“Isıl işlem görmeyen çiğ süt, bakteriler için besi ortamıdır”
Çiğ sütün yapısının bakteriler için uygun bir çoğalma zemini sunduğunu ifade eden Doç. Dr. Yıldırım, sağım ekipmanları, depolama koşulları ve çevresel bulaşmaların risk oluşturduğunu belirterek şu ifadeleri kullandı:
“Isıl işlem görmeyen çiğ süt, bakteriler için doğal bir besi ortamı oluşturur. Bu zengin içerik bakterilerin çoğalmasına imkân sağlar. Pastörizasyon veya kaynatma yapılmadığında süt yalnızca bakterileri değil, onların antibiyotik direnç genlerini de canlı olarak barındırabilir.”
“Doğru ısı ve doğru süre gıda güvenliği için kritik”
Pastörizasyonun ve kontrollü kaynatma işleminin çiğ süt kaynaklı riskleri büyük ölçüde azalttığını ileterek konuşmasını sürdüren Yıldırım:
“Sütün yeterli sıcaklıkta tutulması, ısının öldürücü etkisinin tam olarak ortaya çıkmasını sağlar. Evde yapılan kaynatma işlemi de koruyucu olabilir; ancak doğru sıcaklık ve süre sağlanmadığında bazı bakteriler canlı kalabilir. Pastörizasyon bu süreci standartlaştırır.” dedi.
Çok disiplinli proje de Doç. Dr. Seval Cing Yıldırım’ın yanı sıra: Sinop Üniversitesi’nden Doç. Dr. Zeynep Yeğin ve Dr. Öğr. Üyesi Cumhur Avşar ile İnönü Üniversitesi yüksek lisans öğrencisi Aynur Akan çalışmada araştırmacı olarak yer aldı.